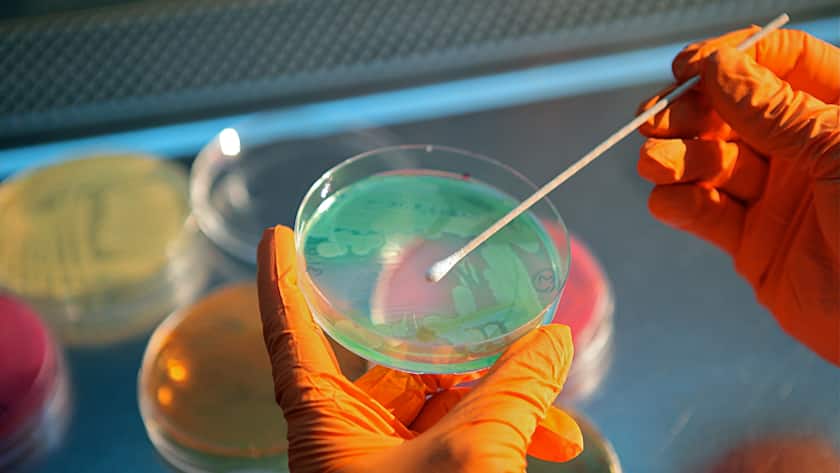
Ein Basilea-Mitarbeiter entnimmt im Labor eine Probe.

Dank der erfolgreichen Nominierung eines Wirkstoffkandidaten fliessen Basilea weitere 7,3 Millionen US-Dollar aus dem CARB-X-Programm (Combating Antibiotic-Resistant Bacteria Biopharmaceutical Accelerator) zu.
CARB-X ist eine global agierende, gemeinnützige partnerschaftliche Initiative, welche die Frühphasen-Entwicklung antibakterieller Wirkstoffe fördert. Konkret wird mit den zusätzlichen Mitteln der neuartige Antibiotika-Kandidat BAL2420 (LptA-Inhibitor) hin zum Beginn der ersten klinischen Studien am Menschen unterstützt. Diese werden für Mitte 2026 erwartet, wie aus einem Communiqué vom Montag hervorgeht.
LptA-Inhibitoren haben den Angaben zufolge das Potenzial, einen ungedeckten medizinischen Bedarf bei der Behandlung schwerer, durch Bakterien verursachter Infektionen im Krankenhaus zu adressieren. So gehöre BAL2420 zu einer der wenigen neuen Antibiotika-Klassen, die sich derzeit in Entwicklung befinden.
Basilea hat das LptA-Antibiotika-Programm Anfang 2024 von der Spexis AG erworben. Im April dieses Jahres gab Basilea bekannt, dass es einen ersten CARB-X-Zuschuss von bis zu 0,9 Millionen US-Dollar zur Unterstützung früher präklinischer Aktivitäten erhalten habe. Der erfolgreiche Abschluss dieser Aktivitäten führte zur Nominierung von BAL2420 als Medikamentenkandidat und zu einer letzten Meilensteinzahlung von Basilea an Spexis.
(AWP)